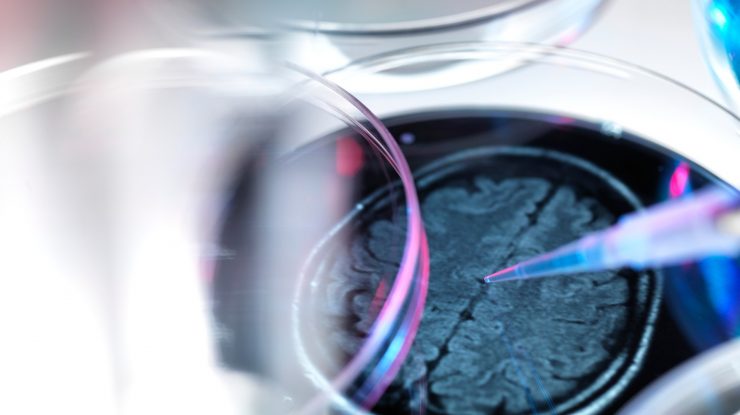
O nouă descoperire arată că apa rece ar putea preveni și trata demența

- În premieră mondială, o proteină „de șoc rece” a fost găsită în sângele înotătorilor de iarnă din Londra.
- Proteina previne apariția demenței și chiar repară unele daune pe care le provoacă boala la șoareci.
- Cercetarea este încă în derulare.
Profesorul Giovanna Mallucci, care conduce Centrul Institutului de Cercetare a Demenței din Marea Britanie la Universitatea din Cambridge, spune că descoperirea ar putea îndrepta cercetătorii spre noi tratamente medicamentoase care ar putea ține demența la distanță, relatează BBC.
Cercetarea – deși promițătoare – este încă în primă fază. Cu toate acestea, se concentrează pe capacitatea de hibernare pe care o au toate mamiferele, iar aceasta este determinată de expunerea la frig.
În Marea Britanie, există deja peste un milion de persoane cu demență și se așteaptă ca totalul să se dubleze până în 2050.
Cercetătorii caută noi modalități de tratare a afecțiunii, deoarece opțiunile actuale au un impact limitat.
Medicii știu de zeci de ani că răcirea oamenilor poate – în anumite circumstanțe – să le protejeze creierul. Persoanele cu leziuni ale capului și cele care au nevoie de operații cardiace sunt adesea răcite în timpul intervenției chirurgicale, la fel și bebelușii.
Ceea ce nu a fost atât de bine înțeles a fost de ce are frigul acest efect protector.
Legătura cu demența constă în distrugerea și crearea sinapselor – conexiunile dintre celulele din creier.
În stadiile incipiente ale Alzheimer-ului și ale altor boli neuro-degenerative, aceste conexiuni ale creierului se pierd.
Acest lucru duce la o cascadă de simptome asociate demenței – inclusiv pierderea memoriei, confuzie și schimbări de dispoziție – și, în timp, moartea celulelor cerebrale întregi.
Ceea ce l-a intrigat pe Profesorul Mallucci a fost faptul că conexiunile creierului nu se pierd atunci când unele animale, cum ar fi urșii, aricii și liliecii, hibernează. Aproximativ 20-30% din sinapsele lor sunt eliminate, deoarece corpurile lor păstrează resurse prețioase pentru iarnă. Dar când se trezesc primăvara, acele conexiuni sunt refăcute în mod miraculos.
Ceea ce arată aceste descoperiri, spune prof. Mallucci, este că – la fel ca mamiferele care hibernează – ființele umane produc proteina „șoc rece”.
Demența este predominant o boală a bătrânilor, astfel încât chiar și o întârziere relativ scurtă la debutul bolii ar putea avea beneficii uriașe pentru indivizi și pentru populația mai largă.